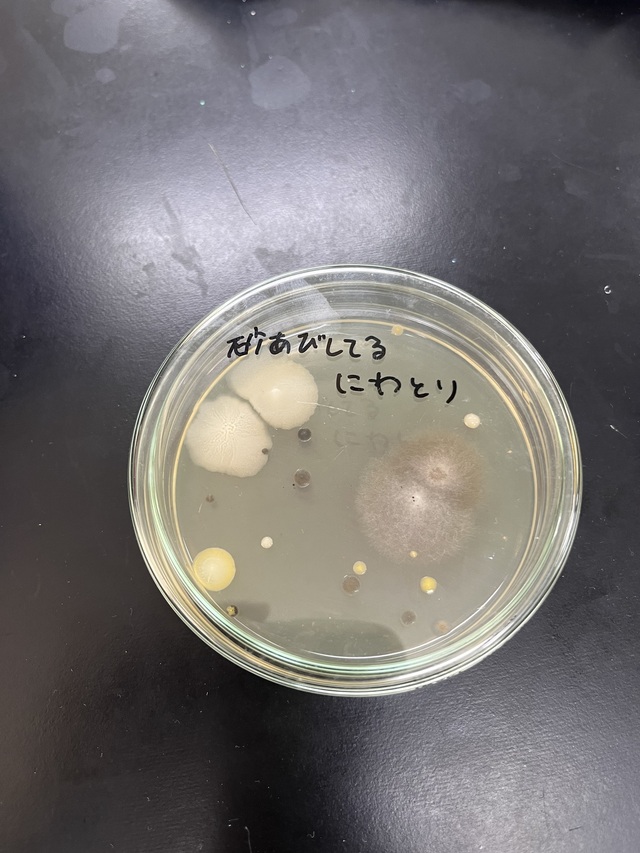
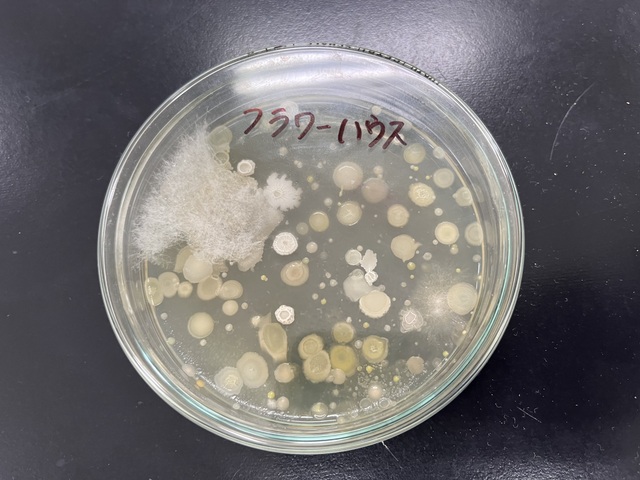

公開日 2025年05月21日
令和7年5月16日(金)・20日(火)2年選択A科目「食品微生物」にて、空気中の落下性細菌の調査をしました。
調査したい場所で5分間、平板培地の蓋をとって採取し、4日間培養して観察をしました。


温室内は、温度と湿度があるため、たくさんの細菌が確認でき、ニワトリが遊ぶ砂場には様々な種類の細菌が確認できました。外に行ったら手洗いをすることの大切さを感じました。
約2週間後に行われる体育大会の会場となるグラウンドは、風が吹いており落下細菌はほとんど見られませんでした。